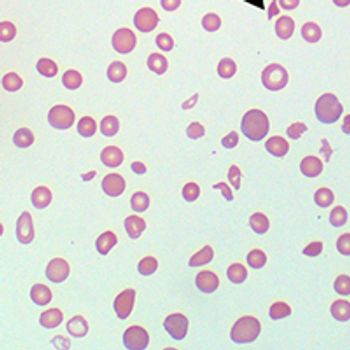

Tucatinib was found to be a potent inhibitor of HER2-mutant signaling in vitro.

Your AI-Trained Oncology Knowledge Connection!


Associate Editorial Director, OncLive®
Kristi Rosa joined MJH Life Sciences in 2016 and has since held several positions within the company. She helped launch the rapidly growing infectious disease news resource Contagion, strengthened the Rare Disease Report, of HCPLive, and now oversees OncLive and its flagship publication OncologyLive. Prior to working at the company, she served as lead copywriter and marketing coordinator at The Strand Theater. Email: krosa@onclive.com

Tucatinib was found to be a potent inhibitor of HER2-mutant signaling in vitro.

The FDA has approved burosumab-twza (Crysvita) injection for the treatment of patients aged 2 and older with tumor-induced osteomalacia, which is described as the development of tumors that cause weakened and softened bones.

The FDA has scheduled an Oncologic Drugs Advisory Committee hearing for July 14, 2020, to discuss data supporting a biologics license application for belantamab mafodotin for the treatment of patients with relapsed/refractory multiple myeloma who have previously received at least 4 prior therapies.

The use of adjuvant immunotherapy in patients with resected stage IIIC melanoma resulted in improved survival benefit, according to real-world data from an early analysis of the National Cancer Database.

The European Medicines Agency has validated and accepted a marketing authorization application for zanubrutinib for the treatment of patients with Waldenström macroglobulinemia who have received at least 1 prior therapy or as frontline treatment for patients who are ineligible for chemoimmunotherapy.

The FDA has granted a fast track designation to fruquintinib for the treatment of patients with metastatic colorectal cancer who have received prior fluoropyrimidine-, oxaliplatin-, and irinotecan-based chemotherapy, VEGF-directed therapy, and EGFR-directed therapy.
The United Kingdom’s National Institute for Health and Care Excellence has chosen not to recommend caplacizumab-yhdp (Cablivi) for use with plasma exchange and immunosuppression in the treatment of acute episodes of acquired thrombotic thrombocytopenic purpura in adults and those aged 12 years and over who weigh at least 40 kg.

The United Kingdom’s National Institute for Health and Care Excellence has recommended entrectinib (Rozlytrek) as a treatment option for ROS1-positive advanced non–small cell lung cancer in adults who have not received prior treatment with ROS1 inhibitors.

The FDA has approved lurbinectedin (Zepzelca) for the treatment of adult patients with metastatic small cell lung cancer with disease progression, following platinum-based chemotherapy.

The FDA has approved an expanded indication for Gardasil 9 for the prevention of oropharyngeal and other head and neck cancers caused by human papillomavirus types 16, 18, 31, 33, 45, 52, and 58.

Endotheliopathy represents a marker of progression to critical illness in patients with COVID-19 infection and soluble thrombomodulin segregates with mortality.

Treatment with the CAR T-cell product lisocabtagene maraleucel led to high response rates, with durable complete responses, in transplant-ineligible patients with relapsed/refractory aggressive B-cell non-Hodgkin lymphoma who had poor prognostic features.

Imetelstat demonstrated meaningful and durable transfusion independence in patients with lower-risk myelodysplastic syndrome that are non-del(5q), dependent on red blood cell transfusion, and are relapsed/refractory to treatment with erythropoiesis-stimulating agents.

The Data and Safety Monitoring Board has advised that the phase 3 DUBLIN-3 trial of the antineoplastic agent plinabulin in patients with advanced or metastatic non–small cell lung cancer who have progressed on standard-of-care therapy can continue without any modifications.

The European Commission has approved encorafenib (Braftovi) in combination with cetuximab (Erbitux) for the treatment of adult patients with BRAF V600E–mutant metastatic colorectal cancer who have received prior systemic therapy.

The FDA has granted a priority review designation to a biologics license application for the investigational, humanized monoclonal antibody naxitamab (Danyelza) for the treatment of patients with relapsed/refractory high-risk neuroblastoma.

The addition of veliparib to cisplatin resulted in a significant improvement in progression-free survival and a trend toward improved overall survival in patients with BRCA-like triple-negative breast cancer.

The highly selective second-generation TKI alectinib demonstrated a clinically meaningful improvement in overall survival compared with crizotinib in patients with ALK-positive non–small cell lung cancer.

Fam-trastuzumab deruxtecan-nxki (Enhertu) demonstrated promising clinical activity in patients with HER2-positive metastatic colorectal cancer, as well as in those with HER2-positive advanced gastric or gastroesophageal junction adenocarcinoma.

Fam-trastuzumab deruxtecan-nxki demonstrated favorable clinical activity with a high objective response rate and durable responses in patients with HER2-mutated non–small cell lung cancer.

Raymond Liu, MD, shed light on the benefits and challenges of utilizing telehealth in oncology and shared advice on how to implement this approach in practice.

Although little evidence exists with regard to how to best treat patients with breast cancer during the COVID-19 pandemic, guidelines have been issued by organizations like ESMO to assist providers with making those decisions.

Neeraj Agarwal, MD, provides insight into olaparib, further discusses the data that led to the regulatory approval, and shares the implications of this approval in metastatic castration-resistant prostate cancer.

Neeraj Agarwal, MD, provides insight into olaparib, further discussed the data that led to the regulatory approval, and shared the implications of this approval in metastatic castration-resistant prostate cancer.

Mary-Beth Percival, MD, provides insight into precautionary measures put into place to ensure patient safety, some of the considerations included in the paper, and the different ways in which she is overcoming challenges faced in practice in light of the pandemic.

John O. Mascarenhas, MD, discusses patient characteristics and outcomes following ruxolitinib discontinuation in myelofibrosis and research efforts being made to address a large unmet need in the space.

Mary-Beth Percival, MD, provides insight into precautionary measures put into place to ensure patient safety, some of the considerations included in the paper, and the different ways in which she is overcoming challenges faced in practice in light of the pandemic.

Nicholas J. Vogelzang, MD, discusses the significance of the rucaparib approval for this patient population.

Maria-Victoria Mateos, MD, PhD, discusses the data that led to the approval of the subcutaneous daratumumab formulation and the clinical implications of the regulatory decision.

Maria-Victoria Mateos, MD, PhD, discusses the data that led to the approval of the subcutaneous daratumumab formulation and the clinical implications of the regulatory decision.